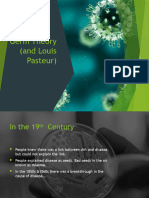

Take notes
Filipino-American doctor-lawyer Samuel Bernal, an expert in the fields of regenerative medicine and
regulatory law, said the public should take a lot of precautions.
“Be careful. Number one, stem-cell therapy is not a ‘cure-all’ (medical procedure),”
“So be careful, especially with any service that offers embryonic stem cells from aborted fetus, or
genetically altered sources and most especially from animal cells,”
Not in any clinic
“Number two precaution, you can’t really get this (stem cell therapy) in any clinic somewhere. Like in a
hotel or a mall,”
Relevant facts
“The goal of stem-cell therapy is not a longevity-anti-aging program. Stem cell therapy is actually trying
to allow the body to heal itself,”
problem
The early-stage stem cells are both difficult and slow to grow. “More important,” says Shamblott,
“there's a risk of tumors. If you're not very careful when coaxing these early cells to differentiate – to
form nerve cells and the like–you risk contaminating the newly differentiated cells with the stem cells.
What are the potential problems with using embryonic stem cells in humans?
For embryonic stem cells to be useful in people, researchers must be certain that the stem cells will
differentiate into the specific cell types desired.
Researchers have discovered ways to direct stem cells to become specific types of cells, such as directing
embryonic stem cells to become heart cells. Research is ongoing in this area.
Embryonic stem cells can also grow irregularly or specialize in different cell types spontaneously.
Researchers are studying how to control the growth and differentiation of embryonic stem cells.
Embryonic stem cells might also trigger an immune response in which the recipient's body attacks the
stem cells as foreign invaders, or the stem cells might simply fail to function normally, with unknown
consequences. Researchers continue to study how to avoid these possible complications.
Why do they exist
The goal of stem-cell therapy is not a longevity-anti-aging program. Stem cell therapy is actually trying to
allow the body to heal itself,
impact
Stem cells have the extraordinary capability to change or differentiate into different cell types in the
body. Since they have the ability to replace dead cells, in adult tissues they serve as an internal repair
system, and this repair function is the basis of the new field of regenerative medicine.
�Introduction:
Stem cells are special type of cells in the body that have the ability to differentiate into other cell/tissue
types. This ability allows them to replace cells that have died. Because of this ability, they have been
tapped to replace or control defective cells/tissues in patients who have certain diseases or defects.
There are three sources of autologous adult stem cells:
1) Bone marrow, harvested by aspiration
2) Adipose tissue (lipid cells), harvested by liposuction, and
3) Blood, collected through leukapheresis - a process where blood is drawn from
the patient, passed through a machine that selects only the stem cells and
returns all other components of the blood back to the patient.
conclusion
Stem cells are unspecialized cells of the human body. They are able to differentiate into any cell of an
organism and have the ability of self-renewal. Stem cells exist both in embryos and adult cells. There are
several steps of specialization. Developmental potency is reduced with each step, which means that a
unipotent stem cell is not able to differentiate into as many types of cells as a pluripotent one. This
chapter will focus on stem cell classification to make it easier for the reader to comprehend the
following chapters.